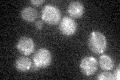
YKR087C
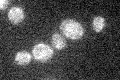
YKR087C

View description
Metalloendopeptidase of the mitochondrial inner membrane, involved in turnover of membrane-embedded proteins; member of a family of predicted membrane-bound metallopeptidases in prokaryotes and higher eukaryotes
Localization:
Intensity:
Fold change:
Significance:
-
C’ GFP library in SD
mitochondria18.45 -
N' NOP1pr-GFP in SD

mitochondria93.4096 -
N' TEF2pr-mCherry in SD

missing0 -
N' NATIVEpr-GFP in SD

mitochondria25.7297 -
N' TEF2pr-VC and Cyto-VN in SD

#N/A0 -
C’ GFP library in SD+DTT

mitochondria17.480.94No -
C’ GFP library in SD+H2O2

mitochondria19.791.07No -
C’ GFP library in Starvation Media
mitochondria18.661.01No -
C’ GFP library on the background of Pup2-DaMP

N/A -
C’ GFP library on the background of CCT mutant

N/A0N/AYes
